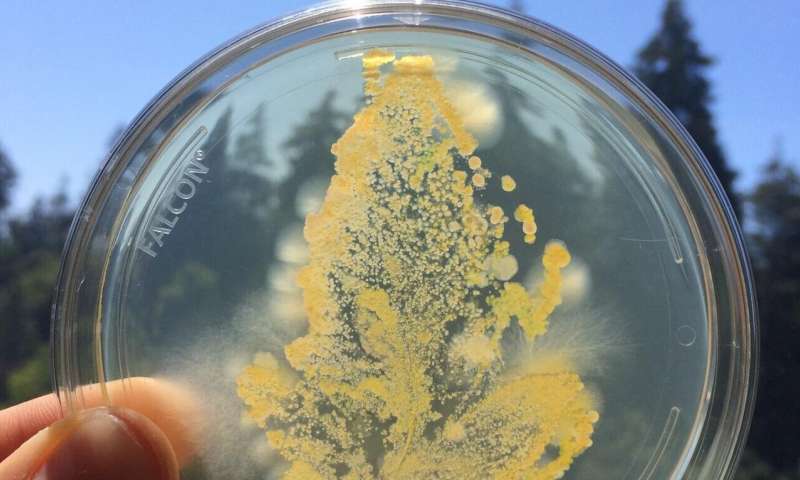
Munagropecuario's tweet image. ¿Cómo se cultiva un microbioma vegetal saludable? - mundoagropecuario.com/como-se-cultiv… Vía @Munagropecuario

METRIX LABORATORIOS
@METRIX_LAB
METRIX Laboratorios es una empresa 100% mexicana, , fundada en 1990, dedicada a la distribución de material y equipo de laboratorio.🔬
You might like
Empieza el día como se merece con una de las mejores cafeteras italianas de inducción muyinteresante.es/bazar/producto…
Descubren un grabado geométrico hecho por neandertales muyinteresante.es/ciencia/articu…
Los cultivos #transgénicos no sólo aportan a una agricultura sustentable, también ayudan en #medicina facilitando la producción de medicamentos y #vacunas de forma eficiente y segura 🧬🌱💉 chilebio.cl/2021/07/07/tu-… | chilebio.cl/2021/05/20/vac… | chilebio.cl/2017/07/28/con… #COVID19

#DíaDeLasTejedoras La hermosa matemática del coral (y el crochet) Una conferencia de @margaretwerth mujeresconciencia.com/2016/12/25/la-…
mujeresconciencia.com
La hermosa matemática del coral (y el crochet) - Mujeres con ciencia
Margaret Wertheim. The Crochet Coral Reef (Institute For Figuring). Matemáticas. Biología marina. Artesanía. Cambio climático. Deshechos plásticos
Actualizando la Teoría de la Evolución > ¿por qué los genes saltan entre cromosomas? ow.ly/fIOa30qnE3y via @tekcrispy #Biología #Genética #Evolución

Los investigadores pueden adivinar la edad de una persona a partir de su microbioma ow.ly/MM3q30qiAwS
infosalus.com
Los investigadores pueden adivinar la edad de una persona a partir...
Investigadores de la Universidad de California en San Diego y la compañía IBM han desarrollado una...
Pregunta a tu ejecutivo por nuestros cubrebocas 📦 con 2,000 pza 👨🏽🔬👨🏽🍳👩🏼⚕️ 👉🏼 metrixlab.mx/contacto/👍🏻 #Ciencia #Higiene #SaludMental #jueves

¿Y sabes qué son las calderas volcánicas? También te enterarás en el enlace 👇
¿Cómo se realiza el monitoreo de los #volcanes activos? Según el Centro Nacional de Prevención de Desastres #Cenapred existen cuatro tipos de monitoreo➡️ bit.ly/2NYo5qL

RT @quironsalud: ¿En qué consiste la vacuna de la #migraña? Te explicamos este reciente tratamiento para prevenir las crisis migrañosas de la mano de Quirónsalud Tenerife y Costa Adeje ow.ly/2HXU50y6E8d

China confirma transmisión de persona a persona del nuevo coronavirus y el contagio de personal médico buff.ly/2GaffBX

🤔Interesante información: una 🔎investigación desarrolla nuevos materiales magnéticos para retirar el petróleo del #agua💦. vía: @iAgua ow.ly/PbIk30qaM3G
iagua.es
Una investigación desarrolla nuevos materiales magnéticos para
Investigadores de las universidades federales de São Paulo (Unifesp) y de Sergipe (UFS), en colaboración con la también federal de São Carlos (UFSCar),...
Los astrónomos creen que los astronautas podrían desenterrar el suministro subterráneo de agua helada con una pala y usarlo como agua potable o combustible para cohetes. 👀 #noticia #actualidad bit.ly/2EfKvyE
¿Cómo se cultiva un microbioma vegetal saludable? - mundoagropecuario.com/como-se-cultiv… Vía @Munagropecuario
Vídeo timelapse de la división de una célula, con sus cuatro fases (profase, metafase, anafase y telofase). 🔬📹: WEHImovies bit.ly/37KoTaT
Tardígrado, conocidos como osos de agua. Se considera uno de los animales más resistentes de la Tierra. La especie 'Hypsibius dujardini' podría sobrevivir a una posible extinción provocada por cualquier posible catástrofe astrofísica. i.imgur.com/3oCObZp.gifv #Biología
¿Necesitamos contar con la #energíanuclear para dejar atrás a los combustibles fósiles? Analizamos su eficiencia, sostenibilidad, rentabilidad económica, seguridad y las perspectivas de futuro. bit.ly/2Wrmfow #ciencia
🤔#SabíasQue Escuchar música activa la misma parte del cerebro que procesa las emociones. 🎶🧠 Checa esto ⬇️ #OnceNoticias
¿Se puede tener miedo a la luna? 😮🤷♀️🌚👻🎃 Vía: bit.ly/2WvCiOV #HappyHalloween #luna #ciencia

#Ciencia Acidificación del agua, causa de la última gran extinción hace 66 millones de años bit.ly/2BFvPrd

United States Trends
- 1. Willie Colón N/A
- 2. Ceballos N/A
- 3. Osasuna N/A
- 4. Spencer Jones N/A
- 5. Carvajal N/A
- 6. Aaron Judge N/A
- 7. Arbeloa N/A
- 8. Alaba N/A
- 9. Asencio N/A
- 10. Justin Crawford N/A
- 11. Tucker N/A
- 12. Mbappe N/A
- 13. Burnley N/A
- 14. Gonzalo N/A
- 15. Dr. Pepper N/A
- 16. ALL RISE N/A
- 17. Royce Lewis N/A
- 18. Tosin N/A
- 19. Ryan O'Hearn N/A
- 20. Fede N/A
Something went wrong.
Something went wrong.




























































































































